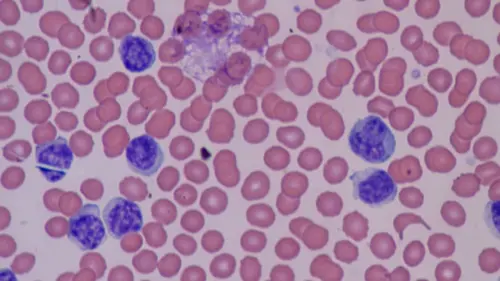
TITOLO
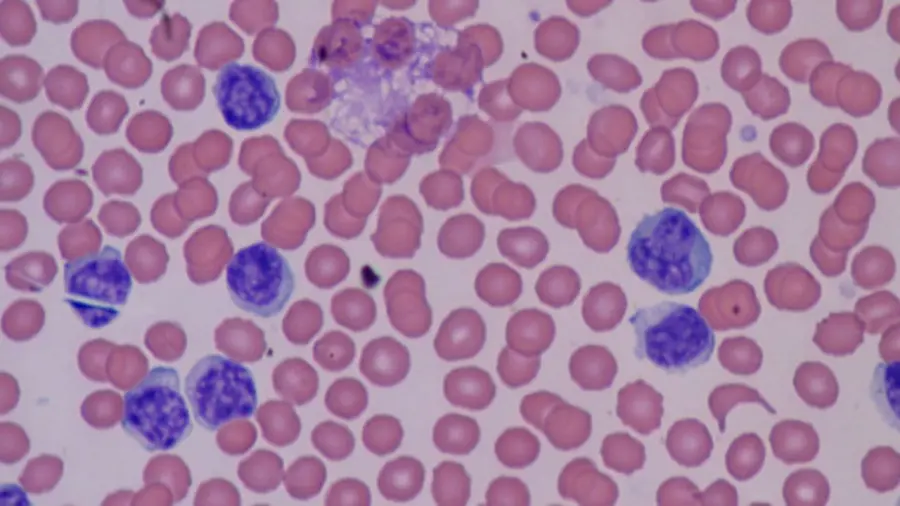
Cos'è la basofilia? Cause e sintomi

Cos'è la basofilia? Cause e sintomi
di Redazione
13/11/2020

Sebbene la basofilia non sia una malattia in sé e per sé, può essere un indicatore importante per altri problemi medici sottostanti. Negli individui sani, i basofili rappresentano una quantità minima della composizione cellulare del corpo. Tuttavia, le persone affette da questa patologia hanno un numero di basofili anormalmente alto. I basofili sono un tipo di globuli bianchi prodotti nel midollo osseo che aiutano l'organismo a combattere le infezioni. Tuttavia, quando una persona è affetta da basofilia, l'aumento dei globuli bianchi può essere dovuto a una causa grave. La basofilia esiste raramente in modo indipendente e più spesso indica la presenza di un'altra condizione.
Cause e fattori di rischio
Le cause più comuni di basofilia riguardano la presenza di infezioni, allergie, disturbi e malattie caratterizzate da infiammazioni croniche o disturbi mieloproliferativi (malattie del sangue e del midollo osseo).Infezioni
Le infezioni spesso innescano una risposta infiammatoria nel corpo che può aumentare le probabilità che una persona sviluppi la basofilia. Tuttavia, lo sviluppo della basofilia a seguito di un'infezione o di una malattia acuta è raro. Alcune malattie, come la varicella e la tubercolosi, possono far pendere l'equilibrio verso la basofilia.Allergie
Allergie e reazioni allergiche a cibo e farmaci possono causare basofilia. La gravità dell'allergia o della risposta può essere associata alla gravità della basofilia.Infiammazione cronica
Molti disturbi e malattie sono direttamente correlati all'infiammazione cronica come artrite reumatoide, psoriasi, malattie infiammatorie intestinali, tiroidite di Hashimoto. Una persona con una condizione caratterizzata da infiammazione può avere maggiori probabilità di sviluppare la basofilia.Disturbi mieloproliferativi
Le malattie mieloproliferative fanno sì che il midollo osseo produca in modo eccessivo diversi tipi di cellule del sangue, compresi i basofili. Questi disturbi possono essere trombocitemia essenziale, leucemia mieloide cronica, mielofibrosi primaria, mastocitosi sistemica o sindrome ipereosinofila.Sintomi
I sintomi della basofilia variano ma possono includere affaticamento, dolore addominale, crampi, perdita di peso inspiegabile, febbre e malessere. Tuttavia, i sintomi che una persona con basofilia sperimenta variano a seconda delle condizioni mediche di base. Le persone che hanno la basofilia a causa di un'infezione avranno sintomi come febbre, affaticamento e malessere generale. Una persona con basofilia a causa di allergie avrà sintomi tipici dell' allergia, tra cui:- raffreddore
- naso chiuso
- prurito agli occhi
- eruzione cutanea o orticaria
- respiro sibilante
- rigonfiamento
 Una persona che ha la basofilia a causa di IBD (malattie infiammatorie croniche intestinali) può sperimentare:
Una persona che ha la basofilia a causa di IBD (malattie infiammatorie croniche intestinali) può sperimentare:
- crampi addominali
- diarrea
- sanguinamento rettale
- dolore nella zona rettale
- fatica
- dolori muscolari e dolori
- rigonfiamento
- leggera febbre
- intorpidimento e formicolio alle mani e ai piedi
- eruzioni cutanee, in caso di psoriasi
- debolezza
- mal di testa
- lividi e sanguinamento facili
- respirazione difficoltosa
- intorpidimento o formicolio alle mani e ai piedi
- dolore alle ossa
Diagnosi
I medici spesso notano la basofilia durante un emocromo completo differenziale. Quando il differenziale rivela alti livelli di basofili, un medico probabilmente prescriverà più test per determinarne la causa. A seconda degli altri sintomi della persona, questi test possono includere una combinazione di quanto segue:- analisi del sangue
- biopsia del midollo osseo
- ecografie e test di imaging
- test genetici
Complicazioni
La basofilia da sola non causa complicazioni ma le cause alla base della basofilia possono esserlo. Le complicanze variano a seconda della causa della basofilia e possono essere gravi. Questi includono quanto segue:- forte sanguinamento
- milza ingrossata
- infezioni frequenti
Trattamento
L'assunzione di antistaminici può aiutare a prevenire i sintomi di allergia e il trattamento si concentrerà sulle condizioni mediche di base della persona. Le infezioni batteriche che causano la basofilia richiederanno antibiotici. Un medico può anche raccomandare riposo e molti liquidi. I trattamenti per le allergie includono:- antistaminici
- crema di idrocortisone
- corticosteroidi
- epinefrina
- chemioterapia
- radioterapia
- trapianti di cellule staminali
- intervento chirurgico per rimuovere la milza
Conclusione
Le prospettive per le persone con basofilia variano a seconda della causa scatenante ma le infezioni lievi dovrebbero risolversi con il riposo e il trattamento. Le malattie infiammatorie e le allergie sono spesso condizioni immutabili per tutta la vita e possono essere controllate con farmaci e cambiamenti nello stile di vita. Le persone con basofilia causata da una condizione grave, come un disturbo mieloproliferativo, dovrebbero infine sviluppare un piano di trattamento personalizzato con il proprio medico.Articolo Precedente
I migliori rimedi naturali per bloccare la caduta dei capelli
Articolo Successivo
Ritardo mentale e quoziente intellettivo
Articoli Correlati

Come affrontare l'Influenza
24/09/2024

Benefici di mangiare una mela al giorno
11/07/2024

